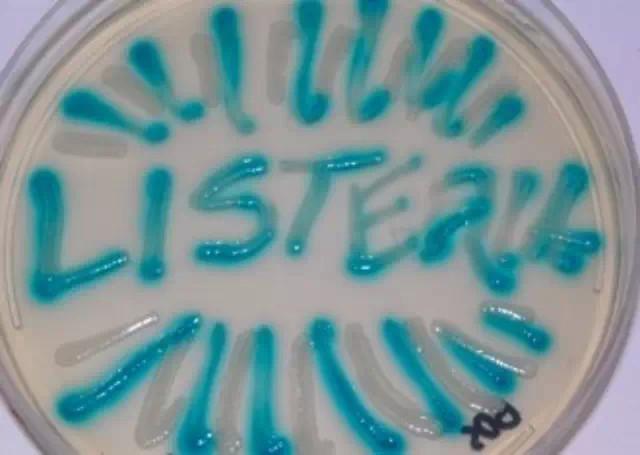

作者:陜西省人民醫院主任藥師 李巧如
盛夏季節,冰箱里的冷飲冷食無疑就會成為大多數人鐘情的消暑食品。但是,在人們盡情享受美食的時候,有一種細菌同樣非常喜歡冰箱的溫度,會在人們毫無知覺的情況下,對人體健康造成危害,這就是李斯特菌。
李斯特菌是一種需氧兼性厭氧革蘭氏陽性桿菌,主要以食物為傳染媒介,是最致命的食源性病原體之一。李斯特菌在自然界中分布較為廣泛,在腐爛的植物、土壤、動物糞便、污水、飼料和水中均可找到其蹤跡。它在5℃~45℃都能生存,最容易污染的食品為乳和乳制品、肉和肉制品、蔬菜、沙拉、海產品和冰淇淋等,尤其是冰箱中保存時間過長的乳制品、肉制品,是最常見的李斯特菌的食物傳染媒介。
因為西方人喜食冷飲,此菌在西方存在爆發流行現象。現如今,隨著我們的飲食習慣,尤其是年輕人的飲食習慣的逐漸西化,此菌的感染率已呈現出逐年上升趨勢,希望大家能予以重視。
李斯特菌主要易感人群為孕婦、新生兒以及免疫功能低下者。感染此菌后的3天~70天產生臨床表現。健康者臨床表現和流感相似,輕者為腹瀉、腹痛、發熱,重者可導致敗血癥、腦膜炎。孕婦感染李斯特菌后,細菌能夠經血液進入胎盤中,孕婦可出現發熱、嘔吐、出血性皮疹、化膿性結膜炎、昏迷以及流產,甚至發生死胎等后果。幸存的新生兒則易因患腦膜炎,導致智力缺陷或死亡。
人們一旦感染了李斯特菌,雖然后果比較嚴重,但其感染可防可控,且治療方法簡單有效。我們在平時生活中注意飲食衛生即可有效預防。
具體做法是:
1.大家在冰箱儲存食物時應做到生熟分開并保持清潔。
2.在烹調食物時,要確保燒熟煮透。
3.冰箱里的剩菜,應將其熱透才能吃。
4.不要喝未經巴氏消毒和徹底煮開的生奶。
5.不要吃沒有經過徹底加熱的肉、火腿、鹵肉等熟食。即使是有密封包裝或有冷藏存放條件的食品。
6.應對家中冰箱里的食物定期進行清理,并定期清潔冰箱。
北青網-北京青年報









